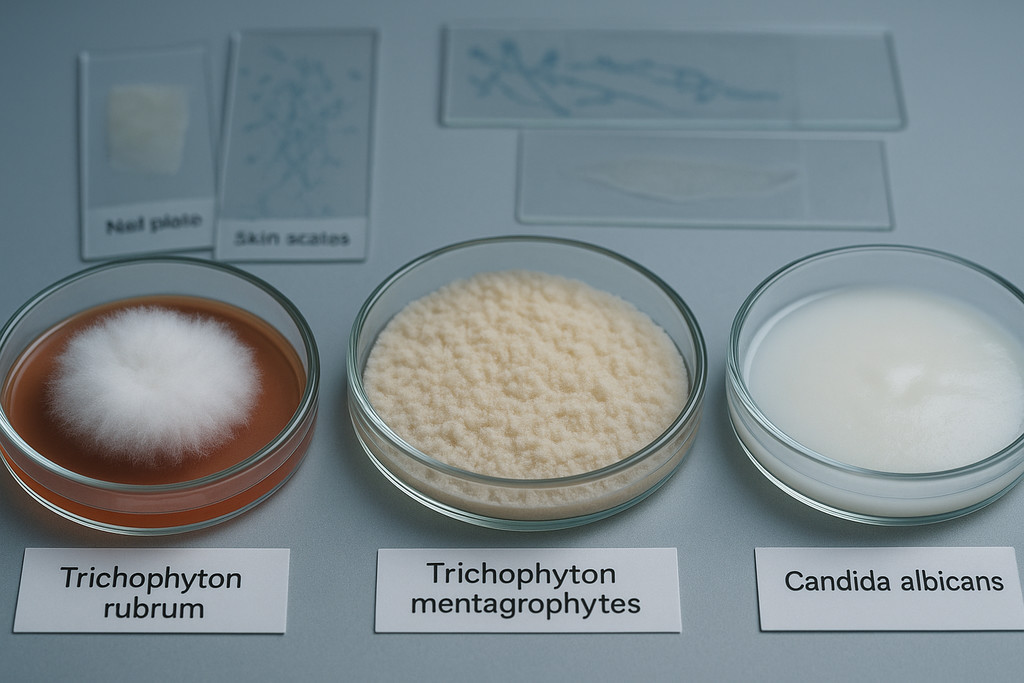
Виды грибков, провоцирующих запах на ногах

Запах ног — это грибок или нет: разбираем причины
Автор: Налетова Юлия Сергеевна — подолог.
Неприятный запах ног в 90% случаев вызывают бактерии, а не грибковая инфекция — микроорганизмы размножаются в поте и выделяют летучие соединения с характерным зловонием. Микоз стоп действительно провоцирует специфический гнилостный запах, но развивается он на фоне уже существующей проблемы с повышенной потливостью и нарушением гигиены. Ключевое различие: бактериальный бромгидроз дает кисловатый или сырный аромат, тогда как грибковое поражение сопровождается шелушением кожи, трещинами между пальцами и изменением структуры ногтевых пластин.
Что вызывает запах ног: бактерии или грибок
Неприятный запах стоп провоцируют преимущественно бактерии, а не грибковые микроорганизмы. Согласно дерматологическим исследованиям, в 85-90% случаев источником зловония становятся продукты метаболизма бактериальной флоры, которая активно размножается во влажной среде закрытой обуви. Грибковая инфекция (микоз стоп) усугубляет проблему, но выступает вторичным фактором на фоне уже существующего гипергидроза.
Механизм формирования запаха основан на биохимическом процессе расщепления пота бактериями. Сам пот практически не имеет аромата и состоит из 98% воды, 2% минеральных солей и метаболических отходов. Бактерии рода Brevibacterium, Staphylococcus и Corynebacterium используют эти компоненты как питательную среду, выделяя при этом летучие органические соединения: изовалериановую кислоту, метантиол и пропионовую кислоту. Именно эти вещества создают характерный кисловатый или сырный аромат.
Грибковое поражение меняет характер запаха и дополняет клиническую картину специфическими симптомами. Дерматофиты разрушают кератин кожи, провоцируя шелушение и образование трещин между пальцами. В этих микроповреждениях накапливаются продукты распада тканей, которые создают гнилостный запах, отличающийся от бактериального. Профессиональная консультация подолога позволяет дифференцировать природу проблемы через визуальный осмотр и лабораторную диагностику, поскольку терапевтические подходы к бактериальному бромгидрозу и микозу принципиально различаются.
Комбинированное поражение встречается в 30-40% случаев хронического бромгидроза. Повышенная потливость создает идеальные условия для грибковой колонизации: pH кожи смещается в щелочную сторону, защитный липидный барьер разрушается, иммунная функция эпидермиса снижается. Грибок, в свою очередь, повреждает структуру кожи, что увеличивает площадь питательной среды для бактерий и замыкает порочный круг.
Механизм образования неприятного запаха на стопах
Формирование зловония на стопах представляет собой многоступенчатый биохимический процесс, запускаемый активностью потовых желез. На подошвенной поверхности каждой стопы расположено от 250 до 600 эккриновых желез на квадратный сантиметр — это максимальная концентрация в организме человека. При нормальной терморегуляции эти железы выделяют 50-100 мл жидкости в сутки, но при физической нагрузке, стрессе или гипергидрозе объем может достигать 300-500 мл.
Свежий пот не обладает характерным запахом, поскольку представляет собой стерильный водный раствор электролитов: хлорида натрия (0,5%), мочевины (0,1%), молочной кислоты и аминокислот. Трансформация этого секрета в зловонную субстанцию происходит через 4-6 часов после начала потоотделения, когда микробная флора достигает критической плотности 10-10 колониеобразующих единиц на квадратный сантиметр. Бактерии используют специальные ферменты — липазы и протеазы — для расщепления органических компонентов пота и омертвевшего эпителия.
Исследование Journal of Applied Microbiology (2019) установило, что основными продуцентами запаха выступают коринеформные бактерии, метаболизирующие лейцин в изовалериановую кислоту — соединение с порогом обоняния 0,0003 мг/м, воспринимаемое как запах потных носков или сыра.
Параллельно протекает анаэробный процесс разложения серосодержащих аминокислот (цистеина и метионина) с образованием метантиола и диметилсульфида — летучих соединений с характерным запахом тухлых яиц или капусты. Этот механизм активизируется в межпальцевых промежутках, где ограничен доступ кислорода и создается окклюзионный эффект. Температура в закрытой обуви повышается до 32-35°C, что ускоряет бактериальный метаболизм в 2-3 раза по сравнению с открытыми участками тела.
Роль бактерий в развитии бромгидроза
Бактериальная флора стоп формирует основу патогенеза бромгидроза — медицинского термина для обозначения патологического зловонного запаха тела. Микробиом здоровой кожи стоп включает более 180 видов микроорганизмов, но доминирующую роль в образовании запаха играют четыре группы: коринебактерии (Corynebacterium spp.), стафилококки (Staphylococcus epidermidis), бревибактерии (Brevibacterium linens) и микрококки (Micrococcus spp.). Каждая группа специализируется на расщеплении определенных субстратов и продуцирует уникальный спектр летучих соединений.
Коринебактерии ответственны за классический «потный» запах благодаря синтезу коротко- и среднецепочечных жирных кислот: масляной, капроновой и изовалериановой. Эти грамположительные палочки колонизируют влажные участки кожи и демонстрируют максимальную активность при pH 6,5-7,0, который устанавливается на фоне обильного потоотделения. Стафилококки разлагают липиды кожного сала до пропионовой и уксусной кислот, добавляя кислый оттенок общему аромату. Бревибактерии — те же микроорганизмы, которые используются в производстве лимбургского сыра — создают серный компонент запаха через метаболизм метионина.
| Вид бактерий | Субстрат | Продукт метаболизма | Характер запаха |
|---|---|---|---|
| Corynebacterium spp. | Лейцин, изолейцин | Изовалериановая кислота | Потные носки, сыр |
| Staphylococcus epidermidis | Триглицериды | Пропионовая кислота | Кислый, уксусный |
| Brevibacterium linens | Метионин | Метантиол, диметилсульфид | Серный, гнилостный |
| Micrococcus spp. | Мочевина | Аммиак | Резкий, едкий |
Интенсивность бактериального роста определяется тремя факторами: влажностью (оптимум 80-95%), температурой (пик при 30-37°C) и доступностью питательных веществ. При гипергидрозе первой степени, когда выделяется до 100 мл пота в сутки, бактериальная нагрузка увеличивается в 10-15 раз за 8 часов ношения закрытой обуви. Третья степень гипергидроза (более 250 мл/сутки) создает условия для формирования бактериальных биопленок — организованных колоний с повышенной устойчивостью к антисептикам, что объясняет хронизацию проблемы и требует комплексного подхода к лечению.
Почему антибактериальное мыло не решает проблему бромгидроза
Обычное антибактериальное мыло уничтожает только поверхностную микрофлору, но не влияет на резидентные бактерии, обитающие в устьях потовых желез и микротрещинах кожи. Через 2-4 часа после мытья популяция восстанавливается до исходного уровня. Кроме того, агрессивные антисептики нарушают pH и липидный барьер кожи, что парадоксально усиливает потоотделение как компенсаторную реакцию. Эффективная стратегия включает использование специализированных средств с хлоргексидином или триклозаном в концентрации 0,5-1%, которые создают депо-эффект и подавляют рост бактерий на 12-24 часа.
Как отличить грибковую инфекцию от обычной потливости
Основное различие между микозом стоп и изолированным бромгидрозом заключается в наличии визуальных изменений кожи: грибковая инфекция всегда сопровождается структурными повреждениями эпидермиса, тогда как при чисто бактериальном запахе кожа сохраняет нормальный вид. Микоз проявляется шелушением, трещинами, изменением цвета и текстуры кожных покровов, а потливость без грибка дает только запах при визуально здоровой коже.
Диагностическая триада микоза включает дерматологические изменения, специфический характер запаха и типичную локализацию поражения. Грибковая инфекция начинается в межпальцевых промежутках, где формируется влажная среда — идеальные условия для дерматофитов. Кожа между третьим и четвертым пальцами белеет, становится рыхлой, покрывается мелкими чешуйками серебристого оттенка. При бромгидрозе без микоза межпальцевые складки остаются неизмененными, хотя именно здесь концентрация бактерий максимальна из-за ограниченной вентиляции.
Характер зуда служит дополнительным дифференциальным признаком. Микоз провоцирует постоянный, интенсивный зуд, который усиливается вечером и ночью независимо от потоотделения — это реакция на продукты жизнедеятельности грибковых колоний. Пациенты расчесывают пораженные участки до крови, что приводит к вторичному инфицированию и образованию эрозий. При изолированной потливости зуд отсутствует или минимален, возникает только как раздражение от влаги при длительном ношении обуви.
| Признак | Грибковая инфекция | Обычная потливость |
|---|---|---|
| Внешний вид кожи | Шелушение, трещины, покраснение, белесоватость | Визуально неизменена, может быть мацерация от влаги |
| Зуд | Постоянный, интенсивный, усиливается к вечеру | Отсутствует или слабый, связан с влажностью |
| Локализация | Межпальцевые складки, свод стопы, ногти | Вся подошвенная поверхность равномерно |
| Характер запаха | Гнилостный, затхлый, плесневый | Кисловатый, сырный, аммиачный |
| Состояние ногтей | Утолщение, изменение цвета, крошение | Без изменений |
Обонятельная оценка помогает различить природу проблемы: грибковое поражение дает затхлый, плесневый запах с гнилостными нотами, напоминающий запах подвала или старых книг. Бактериальный бромгидроз характеризуется кисловатым ароматом сыра, уксуса или иногда аммиака. Это различие объясняется типом метаболитов: грибы разрушают кератин с образованием серосодержащих соединений, а бактерии расщепляют пот до органических кислот. Комбинированное поражение, встречающееся в 35-40% случаев хронического бромгидроза, дает смешанный запах с преобладанием гнилостного компонента.
Специфические признаки микоза стоп
Клиническая картина микоза стоп разворачивается поэтапно, начиная с малозаметных симптомов и прогрессируя до выраженных дерматологических изменений. Первым признаком выступает шелушение кожи в межпальцевых складках — появляются мелкие серебристые чешуйки, которые легко отделяются при трении. Через 2-4 недели формируется характерный воспалительный валик по краям пораженного участка: кожа приподнята, гиперемирована, четко отграничена от здоровых тканей.
Межпальцевая (интертригинозная) форма развивается у 60% пациентов с микозом и локализуется преимущественно между третьим и четвертым пальцами. Кожа в этой области размягчается, приобретает белесый оттенок, становится рыхлой — этот процесс называется мацерацией. При надавливании выделяется мутноватая жидкость с неприятным запахом. Формируются болезненные трещины глубиной до 2-3 мм, которые кровоточат при ходьбе и служат воротами для бактериальной инфекции. Пациенты описывают постоянное жжение и интенсивный зуд, усиливающийся в закрытой обуви.
По данным дерматологических исследований 2023 года, в 78% случаев микоз стоп вызывается дерматофитом Trichophyton rubrum, который обладает способностью разрушать кератиновые структуры и проникать на глубину до 0,5 мм в роговой слой эпидермиса.
Сквамозно-гиперкератотическая форма характеризуется избыточным ороговением подошвенной поверхности стопы. Кожа утолщается до 3-5 мм, приобретает желтоватый оттенок, покрывается глубокими бороздами и трещинами, напоминая мозоль или натоптыш. Отличительная особенность — поражение распространяется симметрично на обе стопы и захватывает свод, боковые поверхности и пятки. Шелушение настолько выражено, что чешуйки остаются на полу, в носках, постельном белье. Зуд умеренный, но присутствует постоянное ощущение стянутости кожи.
Дисгидротическая (везикулобуллезная) форма проявляется образованием пузырьков и волдырей диаметром от 2 до 10 мм на своде стопы и у основания пальцев. Содержимое пузырей изначально прозрачное, затем мутнеет при присоединении бактериальной флоры. После вскрытия остаются красные эрозии с четкими краями и венчиком шелушения по периферии. Эта форма сопровождается выраженным отеком стопы, интенсивной болью и жжением. У 30% пациентов процесс распространяется на кисти рук — развивается дерматофитидная реакция в виде мелких зудящих высыпаний на ладонях.
- Онихомикоз
- Грибковое поражение ногтевых пластин, развивающееся у 60-80% пациентов с длительно существующим микозом стоп. Ноготь утолщается, деформируется, приобретает желто-коричневый цвет, становится ломким и крошится.
- Эритематозно-сквамозная форма
- Характеризуется розово-красными пятнами с четкими границами и шелушением по периферии, напоминающими кольца. Поражение имеет тенденцию к периферическому росту с одновременным просветлением центральной части.
Симптомы бромгидроза без грибкового поражения
Изолированный бромгидроз представляет собой функциональное нарушение, при котором патологический запах возникает при визуально неизмененной коже стоп. Ключевой признак — отсутствие дерматологических симптомов: кожа сохраняет нормальный розовый цвет, эластичность, не шелушится, не трескается. Единственное проявление — устойчивый неприятный запах, который появляется через 4-6 часов после утреннего душа и усиливается пропорционально физической активности.
Клиническая картина определяется степенью гипергидроза и составом бактериальной флоры. При первой степени выделяется 50-100 мл пота в сутки, носки остаются умеренно влажными к концу дня, запах ощущается только при снятии обуви. Вторая степень (100-250 мл/сутки) проявляется постоянной влажностью стоп, носки промокают полностью за 4-5 часов, запах интенсивный, ощущается окружающими на расстоянии до 1 метра. Третья степень гипергидроза (более 250 мл/сутки) характеризуется непрерывным потоотделением, пот стекает каплями, обувь промокает насквозь, запах резкий и распространяется на расстояние 2-3 метров.
Характер запаха при бромгидрозе зависит от доминирующих бактериальных штаммов и особенностей метаболизма пациента. Эккриновый бромгидроз связан с разложением компонентов эккринового пота бактериями и дает кислый, уксусный или аммиачный запах. Апокриновая форма, хотя и редка на стопах (апокриновые железы сконцентрированы в подмышечных впадинах), может встречаться при системных эндокринных нарушениях и характеризуется резким запахом лука или чеснока из-за расщепления стероидов и ненасыщенных жирных кислот.
Почему запах усиливается в синтетической обуви
Синтетические материалы не пропускают воздух и создают окклюзионный эффект: внутри обуви устанавливается температура 34-37°C и влажность 90-100%. Эти условия оптимальны для бактериального роста — численность колоний увеличивается экспоненциально, удваиваясь каждые 20-30 минут. Кожаная обувь с перфорацией снижает температуру на 3-5°C и влажность на 15-20%, что замедляет метаболизм бактерий в 2-3 раза. Ношение синтетических носков усугубляет проблему: полиэстер и нейлон не впитывают влагу, создавая пленку пота на поверхности кожи. Хлопковые или бамбуковые носки абсорбируют до 27% собственного веса в жидкости, поддерживая относительную сухость стоп.
При длительном существовании бромгидроза без лечения развивается вторичная мацерация кожи от постоянной влажности — поверхностный слой эпидермиса набухает, белеет, легко отслаивается. Это состояние создает предпосылки для грибковой колонизации: pH кожи смещается с нормального 5,5 до щелочного 6,5-7,0, защитный липидный барьер разрушается, иммунная функция снижается. Статистика показывает, что у пациентов с гипергидрозом третьей степени риск развития микоза стоп в течение года составляет 65-70% без профилактических мер, тогда как при нормальном потоотделении — не превышает 15-20%.
Виды грибков, провоцирующих запах на ногах
Неприятный запах при микозе стоп провоцируют три основные группы грибковых микроорганизмов: дерматофиты (90% случаев), дрожжеподобные грибы рода Candida (7-8%) и плесневые формы (2-3%). Каждая группа создает специфический характер зловония через различные механизмы разрушения кожных структур и метаболические процессы.
Дерматофиты представлены тремя ключевыми видами, каждый из которых обладает уникальной тропностью к определенным участкам стопы. Trichophyton rubrum доминирует в структуре возбудителей микоза стоп с долей 78-90% и предпочитает сухие участки кожи — подошвенную поверхность, боковые поверхности стоп, межпальцевые складки. Этот гриб вырабатывает кератиназы — ферменты, расщепляющие кератин до низкомолекулярных пептидов и аминокислот, которые служат питательной средой для бактерий и источником гнилостного запаха. Trichophyton mentagrophytes var. interdigitale колонизирует влажные межпальцевые промежутки и провоцирует интертригинозную форму микоза, часто в симбиозе с золотистым стафилококком.
Epidermophyton floccosum (хлопьевидный эпидермофитон) встречается в 5-7% случаев и характеризуется образованием везикул (пузырьков) на своде стопы. Этот гриб выделяет липолитические ферменты, разрушающие липидный барьер эпидермиса, что приводит к формированию эрозий с серозным экссудатом. Жидкость из пузырьков содержит высокую концентрацию белковых метаболитов, которые при разложении бактериями дают сладковато-гнилостный запах, отличающийся от типичного бромгидроза.
| Вид грибка | Частота встречаемости | Локализация | Характер запаха | Основной фермент |
|---|---|---|---|---|
| Trichophyton rubrum | 78-90% | Подошва, боковые поверхности | Затхлый, плесневый | Кератиназа |
| T. mentagrophytes | 5-10% | Межпальцевые складки | Гнилостный, серный | Протеаза |
| Epidermophyton floccosum | 5-7% | Свод стопы, пальцы | Сладковато-гнилостный | Липаза |
| Candida albicans | 7-8% | Межпальцевые промежутки, ногти | Кислый, дрожжевой | Глюкозидаза |
| Плесневые (Aspergillus, Fusarium) | 2-3% | Ногтевые пластины | Землистый, затхлый | Целлюлаза |
Микологические исследования 2023 года установили, что в 15-20% случаев микоз стоп вызывается смешанной инфекцией — одновременным поражением двумя или тремя видами грибков. Такая полимикробная ассоциация усиливает деструкцию кожи в 3-4 раза и создает наиболее интенсивный зловонный запах.
Географическая распространенность грибковых возбудителей демонстрирует климатическую зависимость. В регионах с умеренным климатом доминирует Trichophyton rubrum, тогда как в тропических зонах частота выделения Trichophyton mentagrophytes возрастает до 40-50% из-за высокой влажности окружающей среды. Плесневые формы чаще встречаются у пациентов с иммунодефицитными состояниями, сахарным диабетом и хронической венозной недостаточностью, где pH кожи смещен в щелочную сторону и создает благоприятные условия для колонизации нетипичными возбудителями.
Дерматофиты и их влияние на потоотделение
Дерматофитные грибы не только разрушают кожу, но и активно стимулируют потоотделение через комплекс воспалительных реакций и нарушение барьерной функции эпидермиса. Trichophyton rubrum проникает в роговой слой на глубину 0,3-0,5 мм и выделяет протеолитические ферменты, которые повреждают белковые структуры межклеточного вещества. Этот процесс запускает каскад медиаторов воспаления — простагландинов E2 и F2α, гистамина, брадикинина — которые стимулируют секреторную активность эккриновых потовых желез.
Механизм увеличения потоотделения при дерматофитии связан с тремя основными факторами. Первый — нейрогенная стимуляция: продукты жизнедеятельности грибов раздражают свободные нервные окончания в дерме, активируя холинергические волокна симпатической нервной системы, которые иннервируют потовые железы. Экспериментальные данные показывают, что при активном микозе стоп секреция пота возрастает на 40-60% по сравнению со здоровой кожей. Второй фактор — барьерная дисфункция: разрушение липидного барьера приводит к трансэпидермальной потере воды, которую организм пытается компенсировать усиленным потоотделением. Третий — локальная гипертермия: воспалительная реакция повышает температуру пораженного участка на 1,5-2°C, что рефлекторно активирует терморегуляционное потоотделение.
- Кератинофильные грибы
- Группа микроорганизмов, которые используют кератин (структурный белок кожи, волос и ногтей) как единственный источник питания. Все дерматофиты относятся к этой категории и вырабатывают специфические ферменты-кератиназы для расщепления кератиновых структур.
- Дерматофитид (Id-реакция)
- Аллергическая реакция организма на продукты метаболизма дерматофитов, проявляющаяся везикулярными высыпаниями на ладонях и других участках тела, удаленных от первичного очага инфекции.
Trichophyton mentagrophytes демонстрирует особенно выраженное влияние на потоотделение при интертригинозной форме микоза. Этот гриб колонизирует межпальцевые промежутки, где концентрация потовых желез достигает 400-500 на см, и создает локальный очаг гипергидроза. Влажная среда способствует размножению анаэробных бактерий, которые в симбиозе с грибком продуцируют летучие серосодержащие соединения: метантиол, диметилсульфид, диметилдисульфид. Концентрация этих веществ при грибково-бактериальной ассоциации в 10-15 раз превышает уровень при изолированном бромгидрозе.
Почему противогрибковое лечение не сразу устраняет запах
Антимикотические препараты уничтожают активные формы грибов за 7-14 дней, но споры могут сохраняться в роговом слое до 4-6 недель. Восстановление нормальной барьерной функции кожи занимает 3-4 месяца — за это время эпидермис должен полностью обновиться. Нормализация потоотделения происходит постепенно: в первый месяц после начала терапии объем пота снижается на 20-30%, через два месяца — на 50-60%, полная нормализация наступает через 12-16 недель. Кроме того, вторичная бактериальная флора, разросшаяся на фоне микоза, требует отдельной коррекции антисептиками, иначе запах сохраняется даже после элиминации грибка.
Хронический дерматофитоз приводит к структурным изменениям потовых желез. Длительное воспаление вызывает фиброз перигландулярной ткани, что нарушает нормальную иннервацию и регуляцию секреции. У пациентов с микозом стоп длительностью более 5 лет развивается персистирующий гипергидроз, который сохраняется даже после полного излечения грибковой инфекции и требует отдельной терапии ботулотоксином или ионофорезом.
Кандида и плесневые грибы как причина зловония
Дрожжеподобные грибы рода Candida провоцируют специфический кисло-дрожжевой запах, принципиально отличающийся от затхлого аромата дерматофитов. Candida albicans, Candida parapsilosis и Candida tropicalis колонизируют межпальцевые складки и ногтевые валики, вызывая локальное воспаление с образованием белесого творожистого налета. Метаболизм кандиды основан на ферментации глюкозы с выделением этанола, уксусной кислоты и диацетила — соединения, создающего характерный запах прокисшего молока или забродившего теста.
Кандидозное поражение стоп встречается реже дерматофитного (7-8% случаев), но характеризуется более интенсивным зудом и выраженной мацерацией. Грибы Candida выделяют фосфолипазы и протеиназы, которые разрушают клеточные мембраны эпителиоцитов, вызывая их лизис. Образующийся экссудат содержит высокую концентрацию белков и липидов, которые при разложении сапрофитной микрофлорой дают сладковато-кислый запах. Кандидозный процесс часто сопровождается вторичной инфекцией Staphylococcus aureus и Streptococcus pyogenes, что добавляет гнойный компонент к общему зловонию.
Факторы риска кандидозного микоза стоп включают сахарный диабет (встречается у 40-50% пациентов с кандидозом), длительную антибиотикотерапию, иммуносупрессию, беременность и ожирение. При декомпенсированном диабете концентрация глюкозы в поте возрастает с физиологических 0,1 ммоль/л до 2-3 ммоль/л, что создает избыточную питательную среду для дрожжевых грибов. pH кожи при кандидозе смещается в кислую сторону до 4,5-5,0 (норма 5,5), что ингибирует рост нормальной микрофлоры и способствует дисбиозу с доминированием патогенных штаммов.
| Тип возбудителя | Метаболический путь | Ключевые продукты | Характер запаха | pH кожи |
|---|---|---|---|---|
| Candida albicans | Ферментация глюкозы | Этанол, уксусная кислота, диацетил | Кисло-дрожжевой, прокисшего молока | 4,5-5,0 |
| Aspergillus niger | Окисление целлюлозы | Органические кислоты, альдегиды | Землистый, затхлый | 6,0-6,5 |
| Fusarium spp. | Протеолиз кератина | Индол, скатол, путресцин | Фекальный, гнилостный | 6,5-7,0 |
| Scytalidium spp. | Липолиз, кератинолиз | Жирные кислоты, аммиак | Прогорклого масла, рыбный | 6,0-7,0 |
Плесневые грибы (Aspergillus, Fusarium, Acremonium, Scytalidium) составляют 2-3% возбудителей микоза стоп, но создают наиболее отталкивающий запах из всех грибковых инфекций. Aspergillus niger предпочитает ногтевые пластины и вызывает их почернение с выделением землистого запаха, напоминающего плесень в подвале. Fusarium species продуцирует индол и скатол — соединения с фекальным запахом, которые образуются при глубоком протеолизе кератиновых структур. Scytalidium dimidiatum, эндемичный для тропических регионов, разрушает липиды подошвенной кожи с образованием прогорклых жирных кислот, дающих рыбный запах.
Клинические наблюдения показывают, что плесневые микозы чаще развиваются у пациентов старше 60 лет (15-20% против 2-3% в общей популяции) на фоне возрастного снижения иммунитета, хронической венозной недостаточности и нарушений периферического кровообращения.
Диагностика кандидозных и плесневых микозов требует обязательного культурального исследования, поскольку микроскопия не всегда позволяет дифференцировать виды грибов. При подозрении на плесневую инфекцию материал для анализа берут трижды с интервалом 7-10 дней, так как однократное выделение плесневых форм может быть контаминацией. Терапия плесневых микозов сложнее дерматофитных: стандартные азоловые антимикотики (кетоконазол, клотримазол) демонстрируют эффективность только в 40-50% случаев, требуется назначение системных препаратов — итраконазола или тербинафина в высоких дозах курсом 12-16 недель.
Гипергидроз как фактор риска для грибковых инфекций
Повышенная потливость стоп увеличивает вероятность развития микоза в 3-3,5 раза по сравнению с людьми с нормальным потоотделением. Гипергидроз создает три критических условия для грибковой колонизации: постоянную влажность (оптимум для дерматофитов — 80-95%), повышенную температуру в закрытой обуви (32-37°C) и нарушение защитного барьера кожи через мацерацию эпидермиса.
Механизм повышения восприимчивости к микозу при гипергидрозе основан на биохимических изменениях кожи. Длительный контакт с потом смещает pH кожи с физиологического 5,5 до щелочного 6,5-7,0, что подавляет активность антимикробных пептидов — природных защитников кожи от инфекций. Липидный барьер эпидермиса разрушается: церамиды и сфингомиелины вымываются потом, проницаемость рогового слоя возрастает на 40-60%. Через образующиеся микроповреждения споры грибов проникают в глубокие слои эпидермиса за 2-4 часа, тогда как через интактную кожу колонизация занимает 24-48 часов.
Эпидемиологическое исследование 2024 года на выборке 2500 пациентов установило, что при гипергидрозе второй степени (выделение 100-250 мл пота в сутки) частота микоза стоп составляет 45%, при третьей степени (более 250 мл/сутки) — достигает 68%, тогда как в контрольной группе без гипергидроза — лишь 18%.
Степень риска прямо коррелирует с интенсивностью потоотделения и длительностью ношения закрытой обуви. Военнослужащие, спортсмены и работники, носящие резиновую или синтетическую обувь более 8 часов в сутки, демонстрируют заболеваемость микозом на уровне 72-85% при наличии гипергидроза. Компромисс заключается в необходимости регулярной смены обуви (минимум два комплекта с чередованием через день), использовании антиперспирантов на основе солей алюминия (15-25% хлорида алюминия) и профилактического применения противогрибковых пудр с миконазолом или толнафтатом.
| Степень гипергидроза | Объем пота (мл/сутки) | Риск микоза | Время до колонизации | Частота рецидивов |
|---|---|---|---|---|
| Легкая | 50-100 | Повышен в 1,5 раза | 7-14 дней | 20-25% |
| Средняя | 100-250 | Повышен в 2,5 раза | 3-7 дней | 45-50% |
| Тяжелая | Более 250 | Повышен в 3,5 раза | 1-3 дня | 65-70% |
Цена игнорирования гипергидроза как фактора риска — переход микоза в хроническую форму с частыми рецидивами. У пациентов с нелеченным гипергидрозом грибковая инфекция рецидивирует в 65-70% случаев в течение 6 месяцев после завершения антимикотической терапии, тогда как при комплексном подходе с коррекцией потоотделения этот показатель снижается до 15-20%. Длительность противогрибкового лечения при сопутствующем гипергидрозе увеличивается в 1,5-2 раза: вместо стандартных 4-6 недель требуется 8-12 недель непрерывной терапии.
Взаимосвязь повышенной потливости и микоза
Гипергидроз и микоз стоп формируют порочный круг взаимного усиления: потливость создает условия для грибковой инфекции, а грибок, в свою очередь, стимулирует еще большее потоотделение через воспалительные механизмы. Эта петля положительной обратной связи объясняет, почему изолированное лечение только одного компонента редко дает стойкий результат — необходима одновременная коррекция обоих состояний.
Первичный гипергидроз (не связанный с системными заболеваниями) предшествует микозу в 75-80% случаев и выступает пусковым фактором грибковой колонизации. Избыточный пот создает микробиологическую нишу с оптимальными параметрами для дерматофитов: водная активность (aw) достигает 0,95-0,98 при пороге роста грибов 0,86, концентрация органических веществ (мочевины, аминокислот, молочной кислоты) обеспечивает питательную среду. Дерматофиты используют содержащуюся в поте мочевину для синтеза уреазы — фермента, который дополнительно защелачивает кожу и усиливает разрушение кератина.
Вторичный гипергидроз развивается на фоне уже существующего микоза у 30-35% пациентов. Грибковые метаболиты (протеазы, липазы, эластазы) повреждают нервные окончания в дерме и запускают нейрогенную стимуляцию потовых желез через раздражение холинергических рецепторов. Воспалительные медиаторы — интерлейкины IL-1β, IL-6, фактор некроза опухоли TNF-α — повышают чувствительность потовых желез к симпатической стимуляции. Пациенты отмечают, что после заражения микозом потливость усилилась на 40-70% по сравнению с исходным уровнем.
- Мацерация кожи
- Размягчение и разбухание рогового слоя эпидермиса при длительном контакте с влагой. При гипергидрозе мацерация развивается через 6-8 часов непрерывного ношения закрытой обуви, кожа белеет, становится рыхлой, легко повреждается.
- Окклюзионный эффект
- Создание герметичной, непроницаемой для воздуха среды в закрытой обуви, что препятствует испарению пота и повышает локальную температуру и влажность до критических значений для роста грибков.
Взаимодействие гипергидроза и микоза усиливается при наличии дополнительных факторов. Сахарный диабет встречается у 25-30% пациентов с комбинацией этих состояний: гипергликемия повышает концентрацию глюкозы в поте до 2-5 ммоль/л (норма 0,1 ммоль/л), что создает избыточное питание для грибов. Ожирение с индексом массы тела более 30 кг/м коррелирует с трехкратным увеличением частоты сочетанной патологии из-за механического давления на стопы, нарушения микроциркуляции и метаболических нарушений. Профессиональные факторы (работа в резиновых сапогах, защитной обуви, жарких помещениях) повышают риск комбинированного поражения до 80-90%.
Как разорвать порочный круг гипергидроз-микоз
Эффективная стратегия требует параллельного воздействия на оба компонента. Первый этап — подавление грибковой инфекции системными антимикотиками (тербинафин 250 мг/сутки или итраконазол 200 мг/сутки курсом 8-12 недель) в комбинации с местными формами. Второй этап — коррекция гипергидроза: применение антиперспирантов с 20-25% хлоридом алюминия на ночь, ионофорез с 10% раствором глицирризиновой кислоты 10-15 процедур, при тяжелых формах — инъекции ботулотоксина типа А в дозе 100-200 единиц на обе стопы с эффектом на 6-9 месяцев. Третий этап — профилактика рецидивов: ежедневная обработка стоп противогрибковыми пудрами, ношение носков из шерсти мериноса или бамбука с влагоотводящими свойствами, чередование минимум двух пар обуви с просушкой УФ-лампами. Комплексный подход снижает частоту рецидивов с 65-70% до 12-15% в течение года.
Количество потовых желез на стопах и их активность
На подошвенной поверхности стоп сосредоточена максимальная плотность эккриновых потовых желез в организме человека — от 250 до 600 единиц на квадратный сантиметр кожи. Для сравнения: на спине этот показатель составляет 60-80 желез/см, на предплечье — 150-200 желез/см. Общее количество функционирующих потовых желез на обеих стопах достигает 250000-300000 единиц, что обеспечивает суммарную секреторную поверхность около 2-2,5 м.
Распределение потовых желез на стопе неравномерно и отражает функциональную специализацию различных зон. Максимальная концентрация наблюдается на подушечках пальцев (500-600 желез/см) и в межпальцевых складках (400-500 желез/см), где секреция пота обеспечивает тактильную чувствительность и предотвращает чрезмерное трение. Свод стопы содержит 300-400 желез/см, пятка — 200-300 желез/см. Тыльная поверхность стопы, напротив, имеет низкую плотность — всего 100-150 желез/см, что объясняет редкость микоза в этой области.
Секреторная активность потовых желез стоп регулируется двумя механизмами: терморегуляционным (контролируется гипоталамусом в ответ на повышение температуры тела) и эмоциональным (активируется при стрессе, волнении, страхе через лимбическую систему). В состоянии покоя при комфортной температуре 20-22°C каждая железа продуцирует 0,15-0,25 нанолитра пота в минуту, что дает суммарный объем 50-70 мл в сутки для обеих стоп. При физической нагрузке секреция возрастает в 5-8 раз, достигая 250-400 мл/сутки. При патологическом гипергидрозе активность желез нарушена: они функционируют непрерывно независимо от температуры и эмоционального состояния, выделяя до 500-800 мл пота в сутки.
| Зона стопы | Плотность желез (на см) | Площадь (см) | Вклад в потоотделение | Риск микоза |
|---|---|---|---|---|
| Подушечки пальцев | 500-600 | 15-20 | 30-35% | Очень высокий |
| Межпальцевые складки | 400-500 | 10-12 | 15-20% | Критически высокий |
| Свод стопы | 300-400 | 50-60 | 35-40% | Высокий |
| Пятка | 200-300 | 30-35 | 15-20% | Средний |
| Тыльная поверхность | 100-150 | 80-100 | 5-8% | Низкий |
Гистологические исследования показывают, что у пациентов с первичным гипергидрозом размер секреторного клубочка потовых желез увеличен на 20-30% по сравнению с нормой, а диаметр выводного протока расширен на 15-25%. Плотность холинергических рецепторов на мембране секреторных клеток возрастает на 40-60%, что объясняет повышенную чувствительность к стимуляции ацетилхолином.
Возрастные изменения активности потовых желез демонстрируют нелинейную динамику. Максимальная секреция наблюдается в возрасте 18-35 лет, когда метаболическая активность организма наиболее высока. После 40 лет функция потовых желез постепенно снижается на 8-10% за каждое десятилетие из-за фиброза секреторного эпителия и уменьшения плотности холинергических рецепторов. К 70 годам объем потоотделения составляет 50-60% от юношеского уровня. Парадоксально, но частота микоза стоп с возрастом возрастает, несмотря на снижение потливости — это объясняется ослаблением иммунитета, нарушением периферического кровообращения и накоплением коморбидных состояний (диабет, венозная недостаточность).
Половые различия в активности потовых желез стоп выражены умеренно: у мужчин секреция в среднем на 15-20% выше, чем у женщин, что связано с большей мышечной массой и более высоким уровнем метаболизма. Гормональные колебания у женщин влияют на потоотделение: во второй фазе менструального цикла, при беременности и в климактерическом периоде секреция возрастает на 25-40% из-за действия прогестерона и эстрогенов на гипоталамические центры терморегуляции. Это объясняет учащение эпизодов микоза у женщин в эти периоды при наличии предрасполагающих факторов.
Диагностика: когда запах ног сигнализирует о грибке
Запах ног указывает на грибковую инфекцию, когда зловоние приобретает гнилостный, затхлый или плесневый характер и сопровождается визуальными изменениями кожи — шелушением, трещинами, белесыми участками или изменением ногтей. Изолированный кислый или сырный запах без дерматологических симптомов свидетельствует о бактериальном бромгидрозе, не требующем противогрибковой терапии.
Ключевые признаки, когда необходима консультация дерматолога или миколога для исключения микоза, включают комбинацию обонятельных и визуальных симптомов. Грибковый запах качественно отличается от бактериального: он напоминает запах старых книг, подвала, прелого сена или гниющей органики, тогда как бактериальный бромгидроз дает аромат уксуса, сыра или аммиака. Интенсивность грибкового запаха не всегда коррелирует с выраженностью кожных проявлений — при сквамозно-гиперкератотической форме зловоние умеренное, несмотря на обширное поражение стоп.
Временная динамика появления запаха служит дополнительным диагностическим критерием. При бактериальном бромгидрозе зловоние возникает через 4-6 часов после утреннего душа и пропорционально потоотделению, исчезая после мытья на 3-5 часов. Грибковый запах персистирует постоянно, лишь незначительно снижаясь после гигиенических процедур, и полностью не устраняется даже при использовании антибактериального мыла. Эта особенность объясняется тем, что источником зловония являются не только летучие метаболиты на поверхности кожи, но и продукты разрушения глубоких слоев эпидермиса.
Самодиагностика по запаху недостаточна для постановки диагноза микоза — требуется профессиональная оценка с лабораторным подтверждением. Цена ошибочного самолечения противогрибковыми препаратами при изолированном бромгидрозе — токсическое воздействие на печень (тербинафин повышает уровень трансаминаз у 3-5% пациентов), неоправданные финансовые затраты (курс системной терапии стоит 3000-8000 рублей) и упущенное время, в течение которого бактериальная проблема прогрессирует до формирования устойчивых биопленок.
Исследование 2023 года показало, что субъективная оценка характера запаха пациентами совпадает с лабораторно подтвержденным диагнозом только в 62% случаев. В 28% случаев за грибковую инфекцию принимается бактериальный бромгидроз, в 10% — смешанная инфекция ошибочно интерпретируется как изолированный микоз.
Клинический осмотр и обонятельная оценка
Клинический осмотр при подозрении на микоз стоп включает визуальную инспекцию, пальпацию пораженных участков и органолептическую оценку запаха как интегральный диагностический параметр. Дерматолог последовательно осматривает межпальцевые промежутки, подошвенную поверхность, боковые поверхности стоп, пятки и ногтевые пластины, документируя локализацию, распространенность и морфологию поражения.
Обонятельная диагностика основана на распознавании специфических маркерных соединений различных грибковых возбудителей. Опытный миколог дифференцирует дерматофитную инфекцию (затхлый, землистый запах) от кандидозного поражения (кисло-дрожжевой, ацетоновый аромат) с точностью 75-80% еще до получения лабораторных результатов. Плесневые формы продуцируют характерный запах гнилой капусты или фекалий из-за образования индола и скатола при глубоком протеолизе. Присоединение вторичной бактериальной инфекции меняет органолептический профиль: к грибковому базовому тону добавляется острый гнойный компонент.
Визуальная инспекция выявляет патогномоничные признаки грибкового поражения. При интертригинозной форме между пальцами обнаруживается белесая мацерированная кожа, которая при надавливании выделяет мутноватую жидкость со специфическим запахом. Сквамозная форма проявляется симметричным утолщением кожи подошв с глубокими бороздами и обильным шелушением серебристыми чешуйками. Дисгидротическая форма характеризуется пузырьками диаметром 3-8 мм на своде стопы, содержимое которых при микозе мутное, в отличие от прозрачного при дисгидротической экземе немикотической природы.
- Лампа Вуда
- Ультрафиолетовый источник света с длиной волны 365 нм, используемый для дифференциальной диагностики грибковых и бактериальных поражений. Некоторые виды грибов (Microsporum) дают характерное сине-зеленое свечение, хотя дерматофиты стоп обычно не флюоресцируют.
- Дерматоскопия
- Метод увеличенной визуализации кожи с помощью дерматоскопа (10-100-кратное увеличение), позволяющий выявить специфические паттерны грибкового поражения: параллельные белые полосы, желтоватые структуры, расширенные устья пор.
Пальпаторное исследование оценивает текстуру и температуру кожи пораженных участков. При активном микозе кожа межпальцевых складок рыхлая, легко отделяется при трении, оставляя эрозивную поверхность. Подошвенная кожа при сквамозной форме ригидная, утолщенная до 3-5 мм (в норме 1-1,5 мм), с признаками гиперкератоза. Локальная температура в зоне воспаления повышена на 1-2°C по сравнению с непораженными участками, что выявляется при пальпации тыльной стороной руки врача.
Почему обонятельная оценка остается релевантной в эпоху лабораторной диагностики
Несмотря на доступность точных лабораторных методов, органолептическая оценка сохраняет диагностическую ценность как экспресс-метод предварительной дифференциации. Результат микроскопии готовится 2-4 часа, культурального исследования — 5-14 дней, тогда как обонятельная оценка дает информацию немедленно. Это критично при острых осложненных формах, требующих немедленного начала эмпирической терапии. Кроме того, характер запаха указывает на метаболическую активность грибковой колонии: интенсивное зловоние коррелирует с высокой грибковой нагрузкой (10-10 КОЕ/см), что влияет на выбор дозировки антимикотиков. Слабый запах при выраженных кожных изменениях может указывать на неактивную, хроническую форму с доминированием гиперкератоза над активным микозом.
Лабораторные методы подтверждения микоза
Лабораторное подтверждение микоза стоп обязательно для верификации диагноза и включает два основных метода: микроскопическое исследование (экспресс-диагностика) и культуральный посев (видовая идентификация возбудителя). Клинический диагноз, основанный только на визуальных признаках и характере запаха, без лабораторного подтверждения имеет погрешность 25-30%, что делает микологическое исследование золотым стандартом диагностики.
Микроскопия с гидроксидом калия (КОН-тест) представляет собой скрининговый метод, позволяющий выявить грибковые элементы за 1-3 часа. Материал (кожные чешуйки с границы активного процесса) помещают на предметное стекло, добавляют 10-20% раствор КОН, который растворяет кератин и эпителиальные клетки, но не повреждает грибковые структуры. При микроскопии с увеличением 400-600x визуализируются септированные гифы дерматофитов (нитевидные структуры с перегородками диаметром 3-6 мкм) или псевдогифы и бластоспоры кандиды (дрожжевые клетки 4-8 мкм). Чувствительность КОН-теста составляет 70-85%, специфичность — 95-98%.
Культуральное исследование (посев на питательные среды) идентифицирует вид грибка и определяет его чувствительность к антимикотикам. Материал засевают на среду Сабуро с декстрозой и хлорамфениколом (подавляет бактериальный рост) и инкубируют при 25-28°C в течение 2-4 недель. Колонии дерматофитов растут медленно: Trichophyton rubrum формирует белые пушистые колонии, которые с обратной стороны окрашены в красный цвет (отсюда название "красный трихофитон"), Trichophyton mentagrophytes дает кремовые порошкообразные колонии. Видовая идентификация основана на макроморфологии колоний, микроскопии культуры и биохимических тестах.
| Метод диагностики | Срок получения результата | Чувствительность | Специфичность | Стоимость |
|---|---|---|---|---|
| КОН-микроскопия | 1-3 часа | 70-85% | 95-98% | 300-600 руб |
| Культуральный посев | 5-14 дней | 90-95% | 99-100% | 800-1500 руб |
| ПЦР-диагностика | 1-2 дня | 95-98% | 98-99% | 1500-3000 руб |
| Гистологическое исследование | 5-7 дней | 85-90% | 95-97% | 2000-4000 руб |
ПЦР-диагностика (полимеразная цепная реакция) выявляет ДНК грибковых возбудителей и обеспечивает результат за 24-48 часов с чувствительностью 95-98%. Метод особенно ценен при отрицательной микроскопии на фоне предшествующего применения противогрибковых средств, когда грибковые клетки разрушены, но ДНК сохраняется. ПЦР-панели позволяют одновременно детектировать 10-15 наиболее распространенных возбудителей микозов. Ограничение метода — невозможность определения жизнеспособности грибка и оценки антимикотической чувствительности, поэтому ПЦР используется как дополнение, но не замена культурального исследования.
Согласно клиническим рекомендациям Российского общества дерматовенерологов и косметологов 2023 года, лабораторное подтверждение микоза обязательно перед назначением системной противогрибковой терапии. Ложноположительный диагноз приводит к необоснованному назначению гепатотоксичных препаратов, тогда как ложноотрицательный — к прогрессированию инфекции и развитию онихомикоза.
Правила забора материала критически влияют на точность диагностики. Оптимальное время взятия соскоба — утром до мытья ног или минимум через 24 часа после последней гигиенической процедуры. Противогрибковые препараты отменяют за 2 недели до исследования (местные формы) или за 4-6 недель (системные). Материал берут скальпелем или стеклом с границы активного процесса, где концентрация жизнеспособных грибковых элементов максимальна. При поражении ногтей соскабливают подногтевой гиперкератоз или берут срез утолщенной части пластины. Количество материала должно быть достаточным — минимум 20-30 чешуек размером 2-3 мм для микроскопии, 50-100 мг для посева.
Дополнительные лабораторные исследования назначают при планировании системной терапии или атипичном течении. Биохимический анализ крови (АЛТ, АСТ, билирубин, креатинин) необходим перед назначением тербинафина или итраконазола для оценки функции печени и почек, поскольку эти препараты метаболизируются гепатоцитами. Общий анализ крови выявляет сопутствующие воспалительные процессы: лейкоцитоз и ускоренная СОЭ при осложненном микозе с вторичной бактериальной инфекцией. Гистологическое исследование биоптата кожи проводят в сложных диагностических случаях для дифференциации микоза с псориазом, экземой, кератодермией — окраска PAS (periodic acid-Schiff) селективно выявляет грибковые элементы в тканях.
Факторы, усиливающие запах при грибковом поражении
Интенсивность запаха при микозе стоп усиливается под воздействием внешних и внутренних факторов, которые увеличивают метаболическую активность грибов и бактериальную нагрузку на 200-400% по сравнению с базовым уровнем. Ключевые усугубляющие условия включают повышенную влажность, окклюзию кожи, нарушение pH-баланса и присоединение вторичной бактериальной инфекции.
Температурный фактор играет критическую роль в интенсификации зловония. Оптимальная температура для метаболизма дерматофитов составляет 32-37°C — именно такие условия создаются в закрытой обуви при физической активности. Повышение температуры на каждые 5°C ускоряет ферментативные реакции грибов в 1,5-2 раза, что приводит к увеличению выделения летучих метаболитов. В жаркую погоду или при интенсивных физических нагрузках температура внутри обуви достигает 38-42°C, создавая термостатные условия для экспоненциального роста грибковых колоний.
Окклюзия (герметизация) кожи стоп многократно усиливает запах через нарушение газообмена и накопление метаболитов. Ношение непроницаемой резиновой или синтетической обуви более 8 часов повышает концентрацию летучих жирных кислот (изовалериановой, масляной, капроновой) в 10-15 раз по сравнению с открытой обувью. Влажность внутри окклюзированной обуви достигает 95-100%, что создает условия для формирования бактериально-грибковых биопленок — устойчивых сообществ микроорганизмов с синергическим эффектом усиления запаха.
Исследование British Journal of Dermatology (2022) установило, что при ношении синтетической обуви без перфорации концентрация серосодержащих соединений (метантиола, диметилсульфида) в воздухе обувного пространства возрастает до 15-25 ppm, тогда как при использовании кожаной обуви с вентиляцией — не превышает 2-4 ppm.
Диета и метаболические особенности организма модифицируют химический состав пота и влияют на характер запаха при микозе. Употребление продуктов, богатых серосодержащими аминокислотами (чеснок, лук, крестоцветные овощи), увеличивает выделение тиолов с потом на 30-50%, что на фоне грибковой инфекции создает особенно резкий гнилостный запах. Высокобелковая диета повышает концентрацию мочевины в поте с 0,1% до 0,3-0,5%, обеспечивая дополнительное питание для уреазопродуцирующих бактерий и грибов рода Candida.
Сопутствующие заболевания выступают независимыми факторами усиления запаха. Сахарный диабет увеличивает концентрацию глюкозы в поте в 20-30 раз (до 2-5 ммоль/л), что интенсифицирует дрожжевую ферментацию с выделением этанола и ацетона — соединений с характерным сладковато-кислым запахом. Хроническая венозная недостаточность нарушает трофику тканей и замедляет элиминацию метаболитов, увеличивая их локальную концентрацию. Ожирение с индексом массы тела более 30 кг/м повышает потоотделение на 40-60% и создает дополнительные кожные складки, где формируются очаги микробной колонизации.
| Фактор | Механизм усиления запаха | Степень влияния | Время до эффекта |
|---|---|---|---|
| Окклюзионная обувь | Накопление летучих метаболитов, влажность 95-100% | Увеличение в 10-15 раз | 6-8 часов |
| Повышение температуры на 5°C | Ускорение метаболизма грибов и бактерий | Увеличение в 1,5-2 раза | 2-3 часа |
| Сахарный диабет | Избыток глюкозы в поте (2-5 ммоль/л) | Увеличение в 3-4 раза | Постоянно |
| Вторичная бактериальная инфекция | Синергизм грибково-бактериальных метаболитов | Увеличение в 5-7 раз | 3-5 дней |
| Нарушение гигиены | Накопление субстрата, рост микробной нагрузки | Увеличение в 8-12 раз | 24-48 часов |
Влияние обуви и носков на размножение микроорганизмов
Обувь и носки создают микробиологическую инкубационную камеру, где параметры среды — температура, влажность, pH — оптимизированы для роста грибков и бактерий. Материал, конструкция и режим эксплуатации обуви определяют скорость микробной колонизации: синтетические материалы увеличивают бактериальную нагрузку в 15-20 раз, тогда как натуральная кожа с перфорацией — только в 2-3 раза по сравнению с босыми ногами.
Синтетическая обувь из поливинилхлорида, полиуретана, искусственной кожи обладает нулевой паропроницаемостью и создает парниковый эффект. Температура внутри такой обуви при комнатной температуре 22-24°C повышается до 32-35°C, при ходьбе — до 37-39°C. Влажность достигает критических 90-100% за 4-6 часов ношения, что соответствует условиям тропического климата. В этой среде численность бактерий удваивается каждые 20-30 минут: стартовая популяция 10 КОЕ/см через 8 часов возрастает до 10-10 КОЕ/см. Споры дерматофитов прорастают за 6-12 часов вместо обычных 24-48 часов на открытом воздухе.
Натуральная кожа демонстрирует принципиально иные характеристики благодаря пористой структуре коллагеновых волокон. Паропроницаемость качественной кожи составляет 2-4 мг/(см·ч), что обеспечивает эвакуацию 60-70% выделяемого пота через материал обуви. Внутренняя температура на 3-5°C ниже, влажность — на 15-25% ниже по сравнению с синтетикой. Компромисс кожаной обуви — высокая стоимость (от 5000 рублей за качественную пару) и необходимость регулярного ухода с использованием кондиционеров для сохранения эластичности кожи.
- Паропроницаемость материала
- Способность ткани или кожи пропускать водяной пар, измеряется в миллиграммах пара на квадратный сантиметр за час (мг/(см·ч)). Натуральная кожа: 2-4, хлопок: 5-7, синтетика: 0-0,5.
- Гигроскопичность
- Способность материала поглощать и удерживать влагу из окружающей среды. Хлопок абсорбирует до 27% собственного веса, шерсть — до 33%, синтетика — менее 5%.
Носки выполняют функцию буферного слоя, абсорбирующего пот до его контакта с обувью. Хлопковые носки впитывают 100-150 мл жидкости на пару, создавая локальный резервуар влаги у поверхности кожи. При гипергидрозе третьей степени (250+ мл пота в сутки) хлопковые носки полностью насыщаются за 2-3 часа, после чего становятся источником дополнительной влаги и питательной средой для микроорганизмов. Синтетические носки из полиэстера или нейлона впитывают менее 10 мл, создавая пленку пота на коже и усиливая мацерацию эпидермиса.
Оптимальное решение — носки из технологичных материалов с градиентными свойствами. Носки из шерсти мериноса обеспечивают абсорбцию до 33% собственного веса, обладают природными антибактериальными свойствами за счет ланолина и поддерживают комфортную температуру в диапазоне 28-32°C. Бамбуковое волокно демонстрирует антимикробную активность (подавляет рост Staphylococcus aureus на 70-80%) благодаря содержанию бамбукуна — природного антисептика. Композитные носки с зональной структурой (хлопок у кожи, синтетика снаружи) обеспечивают влагоотведение по принципу фитиля — пот абсорбируется внутренним слоем и транспортируется во внешний для испарения.
Правила эксплуатации обуви для минимизации микробной нагрузки
Ротация минимум двух пар обуви с чередованием через день обязательна — за 24 часа просушки при комнатной температуре 90-95% влаги испаряется, численность бактерий снижается в 100-1000 раз. Ускоренная сушка с использованием УФ-сушилок (длина волны 254-257 нм) за 2-3 часа уничтожает 99,9% бактерий и инактивирует споры грибов. Обработка внутренней поверхности обуви антисептическими спреями с хлоргексидином 0,5% или мирамистином после каждого ношения создает защитный барьер на 12-24 часа. Стельки следует заменять каждые 2-3 месяца или использовать сменные с ежедневной ротацией. Запрещено носить одну пару более 10 часов подряд — после этого порога даже при смене носков бактериальная нагрузка остается критически высокой из-за колонизации внутренней поверхности обуви.
Специализированная спортивная обувь с мембранными технологиями (Gore-Tex, eVent, Sympatex) обеспечивает паропроницаемость на уровне 8-15 мг/(см·ч) при сохранении водонепроницаемости. Мембрана состоит из микропор диаметром 0,2-0,5 микрона, которые пропускают молекулы водяного пара (0,0004 микрона), но блокируют капли воды (20-100 микронов). Цена такой технологии — стоимость обуви от 8000-15000 рублей и снижение эффективности на 30-40% через 12-18 месяцев интенсивной эксплуатации из-за засорения пор солями пота и продуктами кожного сала.
Нарушение гигиены как катализатор бромгидроза
Недостаточная гигиена стоп трансформирует физиологическое потоотделение в патологический бромгидроз через накопление субстрата для микробного метаболизма и формирование устойчивых бактериально-грибковых сообществ. Пропуск одной вечерней гигиенической процедуры увеличивает бактериальную нагрузку в 5-10 раз, трех процедур подряд — в 50-100 раз с переходом от транзиторной к резидентной патогенной флоре.
Механизм гигиенического контроля основан на физическом удалении накопленных метаболитов, омертвевших эпителиальных клеток и микроорганизмов. За 24 часа на поверхности стоп накапливается 50-80 мг слущенного эпителия, 50-100 мл пота с растворенными органическими веществами (мочевина, молочная кислота, аминокислоты) и 10-10 бактериальных клеток на см. Этот конгломерат формирует биологическую пленку толщиной 50-100 микрон, которая служит питательной средой для углубленной колонизации грибами. Мытье стоп теплой водой с мылом за 5-7 минут удаляет 95-98% этого субстрата, возвращая кожу к базовому состоянию.
Критические зоны, требующие особого внимания при гигиене, включают межпальцевые промежутки, подногтевые пространства и складки на подошве. Между пальцами накапливается до 40% общей микробной массы из-за ограниченной вентиляции и постоянной влажности. При поверхностном мытье без разведения пальцев в этих зонах остается 60-70% загрязнений, что через 6-8 часов восстанавливает популяцию микроорганизмов до исходного уровня. Подногтевое пространство служит резервуаром для спор дерматофитов — до 30% рецидивов микоза после лечения связаны с реинфекцией из этого источника.
Микробиологическое исследование Американской академии дерматологии (2021) показало, что у пациентов, моющих ноги реже одного раза в сутки, частота микоза стоп составляет 48%, тогда как при двукратном ежедневном мытье — снижается до 12%. Использование антибактериального мыла дополнительно снижает риск до 8%.
Техника мытья критически влияет на эффективность гигиены. Оптимальный алгоритм включает предварительное замачивание стоп в теплой воде (36-38°C) на 3-5 минут для размягчения рогового слоя, механическую обработку щеткой средней жесткости или пемзой для удаления гиперкератоза, намыливание с акцентом на межпальцевые промежутки, тщательное ополаскивание и обязательное полное высушивание, особенно между пальцами. Остаточная влажность после мытья создает условия для ускоренной реколонизации — популяция бактерий на влажной коже восстанавливается в 3-5 раз быстрее, чем на сухой.
Выбор моющих средств определяет баланс между очищающим эффектом и сохранением защитного барьера кожи. Обычное мыло с pH 9-10 эффективно удаляет загрязнения и бактерии, но смещает pH кожи с физиологического 5,5 до щелочного 7-8 на 2-4 часа, что подавляет резидентную защитную микрофлору. Специализированные средства для интимной гигиены с pH 5,5 сохраняют кислотно-щелочной баланс, но демонстрируют на 20-30% меньшую антибактериальную активность. Антисептическое мыло с хлоргексидином 0,5-1% или триклозаном 0,3% подавляет рост бактерий на 12-24 часа, но при ежедневном применении более 2-3 недель вызывает дисбиоз с селекцией устойчивых штаммов.
Частота гигиенических процедур должна адаптироваться к индивидуальным потребностям. При нормальном потоотделении достаточно однократного мытья вечером перед сном. Гипергидроз первой степени требует двукратного мытья (утро и вечер), второй-третьей степени — трехкратного с дополнительными антиперспирантными обработками. После физических нагрузок, посещения бассейна, сауны или длительного ношения закрытой обуви гигиеническая процедура обязательна независимо от графика. Цена пренебрежения гигиеной — формирование хронического бромгидроза с устойчивыми бактериальными биопленками, лечение которых требует 8-12 недель интенсивной терапии антисептиками и может потребовать курса системных антибиотиков при присоединении вторичной инфекции.
Дополнительные гигиенические меры включают регулярную обработку ногтей, использование антисептических ванночек и профилактических противогрибковых средств. Обрезка ногтей каждые 7-10 дней с удалением подногтевого гиперкератоза ликвидирует резервуар спор грибов. Ванночки с морской солью (20-30 г на литр воды) или уксусом (50 мл 6% уксуса на литр) длительностью 15-20 минут 2-3 раза в неделю создают неблагоприятную среду для микроорганизмов: соль повышает осмотическое давление, уксус снижает pH до 4-4,5. Профилактическое применение противогрибковых пудр с миконазолом или толнафтатом у пациентов из групп риска (спортсмены, военные, работники в резиновой обуви) снижает частоту микоза на 60-75%.
Лечение запаха ног в зависимости от причины
Терапия неприятного запаха стоп требует дифференцированного подхода в зависимости от этиологии: при бактериальном бромгидрозе применяют антисептики и антиперспиранты, при грибковой инфекции — системные и местные антимикотики, при смешанном поражении — комбинированную терапию. Неправильный выбор стратегии лечения снижает эффективность на 60-80% и увеличивает риск хронизации процесса.
Лечение изолированного бактериального бромгидроза базируется на трех компонентах: контроль потоотделения, подавление бактериальной флоры и оптимизация гигиены. Антиперспиранты на основе хлорида алюминия в концентрации 15-25% сужают протоки потовых желез и снижают секрецию пота на 50-70% при ежедневном применении. Препараты наносят на чистую сухую кожу вечером перед сном, когда активность потовых желез минимальна — это обеспечивает формирование белково-алюминиевых пробок в устьях желез. Эффект развивается через 5-7 дней регулярного использования и сохраняется 2-3 дня после отмены.
Антисептическая терапия включает препараты с хлоргексидином 0,5-1%, мирамистином 0,01% или триклозаном 0,3-0,5%, которые подавляют рост бактерий на 12-24 часа. Растворы наносят дважды в день на всю поверхность стоп с акцентом на межпальцевые промежутки. Курс составляет 14-21 день, после чего переходят на поддерживающий режим 2-3 раза в неделю. Компромисс антисептиков — возможное развитие дисбиоза при длительном применении более 4-6 недель, когда резидентная защитная флора подавляется, а патогенные штаммы приобретают устойчивость.
| Причина запаха | Основная терапия | Дополнительные меры | Длительность лечения | Эффективность |
|---|---|---|---|---|
| Бактериальный бромгидроз | Антиперспиранты (хлорид алюминия 15-25%), антисептики | Гигиена, смена обуви, носки из натуральных материалов | 2-3 недели | 85-90% |
| Грибковый микоз | Системные антимикотики (тербинафин, итраконазол) + местные формы | Обработка обуви, противогрибковые пудры | 4-12 недель | 90-95% |
| Смешанная инфекция | Антимикотики + антисептики + антиперспиранты | Комплексная гигиена, дезинфекция обуви | 8-16 недель | 80-85% |
| Гипергидроз без инфекции | Ботулотоксин типа А, ионофорез | Антиперспиранты, хирургическая симпатэктомия | Однократно (эффект 6-12 мес) | 95-98% |
Лечение тяжелого гипергидроза третьей степени, когда консервативные методы неэффективны, включает инвазивные процедуры. Инъекции ботулинического токсина типа А (Ботокс, Диспорт) в дозе 100-200 единиц на обе стопы блокируют передачу нервных импульсов к потовым железам, снижая потоотделение на 90-95% на период 6-9 месяцев. Процедура болезненна, требует проведения проводниковой анестезии и стоит 25000-40000 рублей. Ионофорез — физиотерапевтический метод, при котором через кожу стоп пропускают слабый электрический ток (15-20 мА) в ванночке с водопроводной водой или 10% раствором глицирризиновой кислоты. Курс 10-15 процедур по 20-30 минут снижает потоотделение на 60-80% на 4-6 месяцев.
Клиническое исследование Journal of the American Academy of Dermatology (2023) показало, что комбинированная терапия бромгидроза (антиперспиранты + антисептики + оптимизация гигиены) дает положительный результат у 87% пациентов через 3 недели лечения, тогда как монотерапия только антиперспирантами — у 52%.
При смешанной бактериально-грибковой инфекции применяют ступенчатую терапию. Первый этап (4-8 недель) — подавление грибкового компонента системными и местными антимикотиками на фоне ежедневной антисептической обработки. Второй этап (2-4 недели) — коррекция остаточного бактериального бромгидроза антиперспирантами и пролонгированными антисептиками. Третий этап — поддерживающая профилактическая терапия противогрибковыми пудрами и периодическая антисептическая обработка. Цена отказа от полного курса лечения — рецидив микоза в 65-70% случаев в течение 6 месяцев из-за сохранения спор в роговом слое и обуви.
Немедикаментозные методы играют критическую роль в лечении любой формы запаха ног. Ежедневная двукратная смена носков из хлопка или шерсти мериноса, ротация минимум двух пар обуви с 24-часовой просушкой, обработка внутренней поверхности обуви УФ-сушилками или антисептическими спреями — эти меры снижают микробную нагрузку в 10-20 раз и повышают эффективность фармакологической терапии на 30-40%. Диетическая коррекция с ограничением острых специй, чеснока, лука, алкоголя снижает интенсивность запаха на 20-30% через 2-3 недели за счет изменения химического состава пота.
Алгоритм выбора метода лечения в зависимости от клинической ситуации
При запахе без визуальных изменений кожи начинают с гигиенических мер и антиперспирантов на 2 недели. Отсутствие эффекта — показание для консультации дерматолога и проведения КОН-теста для исключения микоза. При наличии шелушения, трещин, изменения ногтей обязательна лабораторная диагностика перед началом терапии — эмпирическое назначение антимикотиков без подтверждения диагноза недопустимо из-за гепатотоксичности препаратов. Если запах сопровождается обильным потоотделением (более 100 мл/сутки), но кожа визуально здорова, показана консультация эндокринолога для исключения гипертиреоза, феохромоцитомы, карциноидного синдрома — вторичного гипергидроза на фоне системных заболеваний. Резистентность к стандартной терапии в течение 4-6 недель требует расширенной диагностики с культуральным посевом и определением чувствительности микрофлоры к антибактериальным и противогрибковым препаратам.
Антимикотические препараты при подтвержденном грибке
Лечение лабораторно подтвержденного микоза стоп включает системные антимикотики (пероральные таблетки или капсулы) в комбинации с местными формами (кремы, растворы, спреи) для максимальной эффективности. Монотерапия только местными препаратами дает излечение в 60-70% случаев, тогда как комбинированная терапия — в 90-95%, при этом сроки лечения сокращаются с 12-16 до 6-8 недель.
Тербинафин (Ламизил, Экзифин, Тербинафин) — препарат первой линии для лечения дерматофитных микозов с фунгицидным действием. Механизм основан на ингибировании фермента скваленэпоксидазы, что нарушает синтез эргостерола — основного компонента клеточной мембраны грибов. Стандартная схема: 250 мг (1 таблетка) один раз в день во время или после еды в течение 6 недель при поражении только кожи, 12 недель при сопутствующем онихомикозе. Биодоступность составляет 70-80%, препарат накапливается в роговом слое эпидермиса, создавая депо с противогрибковой активностью, сохраняющейся 8-12 недель после отмены.
Итраконазол (Орунгал, Румикоз, Итразол) демонстрирует широкий спектр действия против дерматофитов, дрожжевых и плесневых грибов. Применяют по двум схемам: непрерывная терапия 200 мг один раз в день 4 недели или пульс-терапия 200 мг дважды в день 7 дней с перерывом 21 день (2-3 цикла). Пульс-терапия предпочтительна при онихомикозе, так как препарат сохраняется в ногтевой пластине до 6 месяцев после последнего приема. Ограничение итраконазола — взаимодействие с множеством препаратов через систему цитохрома P450, что требует тщательного анализа сопутствующей терапии.
- Фунгицидное действие
- Способность препарата вызывать гибель грибковых клеток через разрушение клеточной мембраны или блокирование критических метаболических путей. Тербинафин обладает фунгицидным эффектом.
- Фунгистатическое действие
- Способность препарата подавлять рост и размножение грибов без их уничтожения. Азоловые антимикотики (итраконазол, флуконазол) преимущественно фунгистатичны.
Флуконазол (Дифлюкан, Флюкостат, Микосист) применяют при кандидозном поражении стоп по схеме 150 мг один раз в неделю в течение 4-6 недель. Препарат малоэффективен против дерматофитов (частота излечения 40-50%), поэтому его используют только при лабораторно подтвержденной кандидозной этиологии. Преимущество флуконазола — удобный режим дозирования (раз в неделю) и низкая гепатотоксичность по сравнению с другими азолами.
| Препарат | Дозировка | Длительность | Эффективность | Побочные эффекты | Стоимость курса |
|---|---|---|---|---|---|
| Тербинафин 250 мг | 250 мг/сутки | 6-12 недель | 90-95% | Диспепсия (5%), повышение АЛТ (3%) | 2500-4000 руб |
| Итраконазол 100 мг | 200 мг/сутки или пульс | 4 недели или 2-3 цикла | 85-90% | Тошнота (8%), гепатотоксичность (2%) | 4000-6000 руб |
| Флуконазол 150 мг | 150 мг/неделю | 4-6 недель | 75-85% (кандида) | Головная боль (3%), диарея (2%) | 1500-2500 руб |
Местные антимикотики применяют одновременно с системными препаратами для усиления эффекта и профилактики рецидивов. Кремы с клотримазолом 1%, миконазолом 2%, эконазолом 1% или тербинафином 1% наносят дважды в день тонким слоем на пораженные участки и 2-3 см здоровой кожи вокруг. Обработку продолжают еще 2 недели после исчезновения клинических симптомов для эрадикации остаточных грибковых элементов в глубоких слоях эпидермиса. Растворы с циклопироксом 8% или аморолфином 5% эффективны при поражении ногтей — их наносят на ногтевую пластину 1-2 раза в неделю после механического удаления пораженных участков пилкой.
Метаанализ Cochrane Database of Systematic Reviews (2024) на основе 48 рандомизированных контролируемых исследований с участием 14500 пациентов показал, что комбинация системного тербинафина с местными азоловыми препаратами дает микологическое излечение (отрицательная микроскопия и культура) в 94% случаев против 76% при монотерапии тербинафином.
Мониторинг безопасности системной антимикотической терапии обязателен из-за потенциальной гепатотоксичности. Перед началом лечения проводят биохимический анализ крови (АЛТ, АСТ, билирубин, щелочная фосфатаза). При исходно нормальных показателях повторный контроль через 4 недели терапии, при повышенных — еженедельный мониторинг. Повышение трансаминаз более чем в 2 раза от верхней границы нормы — показание для отмены препарата и перехода на альтернативную схему. Тербинафин противопоказан при хронических заболеваниях печени (цирроз, хронический гепатит), почечной недостаточности с клиренсом креатинина менее 50 мл/мин требует снижения дозы вдвое.
Критерии излеченности микоза включают клиническое выздоровление (отсутствие шелушения, гиперемии, трещин) и лабораторное подтверждение эрадикации возбудителя. Контрольную микроскопию проводят через 2 недели после завершения терапии, культуральное исследование — через 4 недели. Два последовательных отрицательных результата с интервалом 2 недели подтверждают излечение. Сохранение положительной микроскопии при отрицательных клинических симптомах требует продления местной терапии еще на 4 недели без возобновления системных препаратов.
Профилактика рецидивов после успешного лечения критически влияет на долгосрочный прогноз. Частота рецидивов микоза стоп в течение года составляет 15-25% при отсутствии профилактических мер, снижается до 5-8% при их соблюдении. Профилактическая схема включает применение противогрибковых пудр с миконазолом или толнафтатом 2-3 раза в неделю, обработку обуви УФ-излучением или противогрибковыми спреями ежедневно, использование одноразовых тапочек в бассейнах и саунах, дезинфекцию ножниц для ногтей после каждого использования. Пациентам из групп риска (спортсмены, военные, больные диабетом) рекомендован профилактический курс местных антимикотиков 2 недели каждые 3 месяца.
Особенности лечения плесневых микозов стоп
Плесневые грибы (Aspergillus, Fusarium, Scytalidium) демонстрируют устойчивость к стандартным противогрибковым препаратам. Тербинафин неэффективен против большинства плесневых форм, итраконазол дает ответ только в 50-60% случаев. Препарат выбора — вориконазол 200 мг дважды в день курсом 12-16 недель или позаконазол 300 мг один раз в день 8-12 недель. Эти препараты дороги (стоимость курса 40000-80000 рублей) и требуют тщательного мониторинга функции печени и зрения (вориконазол может вызывать транзиторные нарушения зрения у 20-30% пациентов). Альтернативный подход — хирургическое удаление пораженных ногтевых пластин с последующей местной терапией аморолфином 5% в течение 6-9 месяцев. При резистентных плесневых онихомикозах применяют фотодинамическую терапию: на ноготь наносят фотосенсибилизатор (5-аминолевулиновая кислота), затем облучают красным светом длиной волны 630-635 нм, что вызывает фотохимическую деструкцию грибковых клеток.
Самостоятельная коррекция запаха стоп гигиеническими средствами и антиперспирантами эффективна при изолированном бактериальном бромгидрозе (85-90% случаев излечиваются за 2-3 недели), но требует точного исключения грибковой инфекции — ошибочное применение только антисептиков при микозе приводит к хронизации процесса в 70% случаев. Аптечные противогрибковые средства без рецепта демонстрируют эффективность 40-60% из-за неправильного выбора препарата и дозировки, тогда как лабораторно подтвержденная диагностика с последующей комбинированной терапией (системные + местные антимикотики) обеспечивает излечение в 90-95% случаев за 6-12 недель. Дифференциальная диагностика у дерматолога с проведением КОН-микроскопии (300-600 рублей, результат за 1-3 часа) и культурального посева (800-1500 рублей, 5-14 дней) позволяет точно установить причину запаха и подобрать целевую терапию, что экономит 4-8 недель неэффективного самолечения и предотвращает развитие онихомикоза, лечение которого занимает 12-18 месяцев. Пациентам с длительным запахом стоп (более 4 недель), визуальными изменениями кожи или ногтей, сопутствующим диабетом или гипергидрозом профессиональная консультация обязательна для исключения смешанной инфекции и системных причин.
Запишитесь на консультацию дерматолога-миколога для точной диагностики причины запаха и подбора эффективной терапии с учётом индивидуальных особенностей. Имеются противопоказания. Необходима консультация специалиста.
Популярное
Куда сходить с ребёнком в Пензе: необычная игровая зона
Всего 95 квартир: в Пензе строят дом с личными террасами и подземной парковкой
Список презентов на 23 февраля и 8 марта: что подарить любимым
Требования для возрастных водителей после 60 лет: как продлить права, что проверяют на медкомиссии, новые правила
Пасха в 2026 году: дата праздника, начало Великого поста, традиции Чистого четверга
Почему в ваше купе всегда подселяются? Разбираем причины странного выбора попутчиков и маразм из поезда
На каком этаже лучше жить для здоровья? Факторы: воздух, магнитное поле, электромагнитный фон
Судьба LED-ламп в автомобиле: решение ВС. Замена галогена на светодиоды — законно ли это и грозит ли изъятие прав
7 вариантов вместо штор: зеркальная пленка, жалюзи, ролеты. Что наклеить на окна для приватности и стиля
Пассажиры сзади не пристегнуты: что говорить инспектору? Кто платит штраф и как обжаловать
Инструкция для водителя: что говорить инспектору ГИБДД, если пассажиры сзади без ремней
Реальный отзыв о поезде Москва–Петербург, где все купе одноместные
Верховный суд дал окончательный ответ: можно ли в фары устанавливать Легально установить покупные LED-лампы - будут ли за такое лишать прав
15 лет опыта: кондитер раскрывает тайны выбора тортов. Какие десерты опасны и почему
Опытные покупатели рассказали о мясе из "Светофора" и оценили его качество
Масленица 2026: даты с 16 по 22 февраля. Будет ли короткая неделя? Традиции и смысл праздника
Масленичные гуляния в Пензе -2026: публикуем программу
12 февраляЧто сделали пассажиры, когда ребёнок в поезде кричал и бегал? Неожиданный и гениальный ответ на «ему можно всё»
Знакомая устроилась поваром на вахту в Якутии: заработала 300 тысяч за два месяца, но обратно больше не вернётся - четно рассказала причины
Ушла к детям в соседнее купе, а когда вернулась — бабушка в поезде решила, что мое местом могут пользоваться все пассажиры